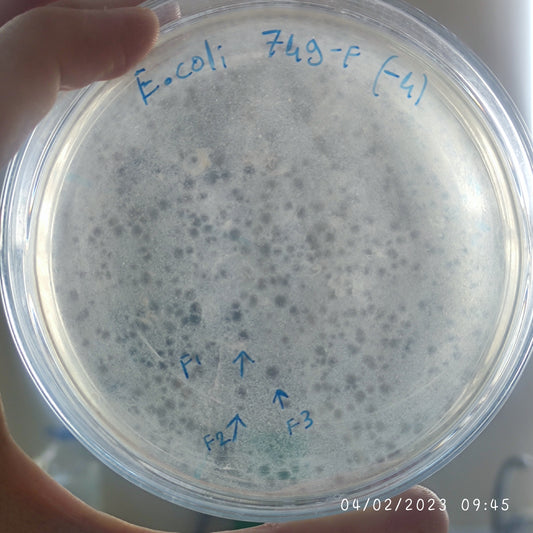
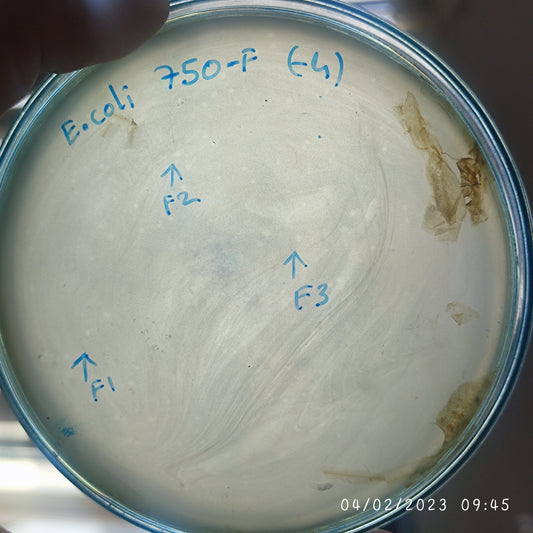
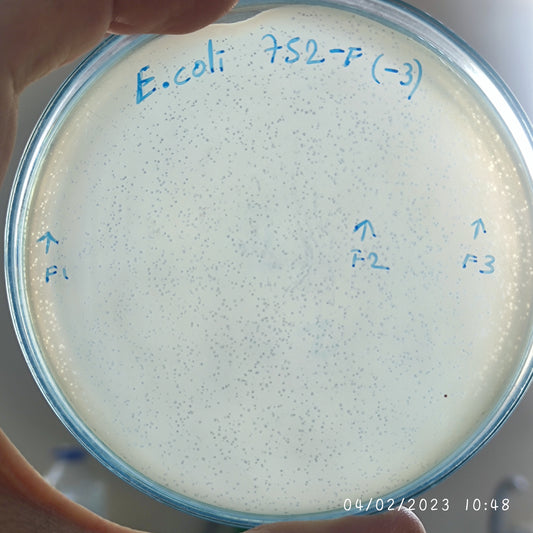
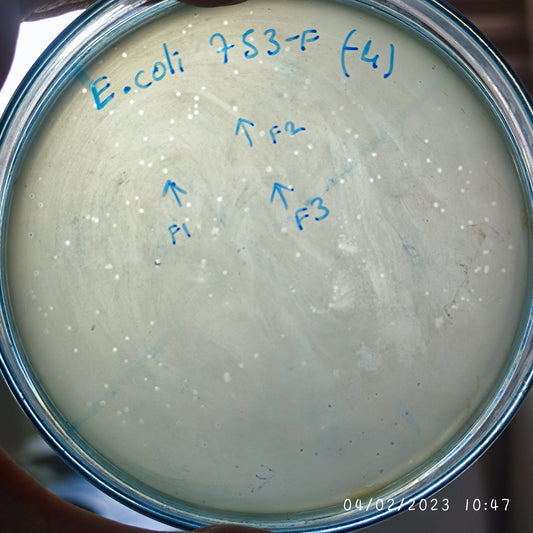
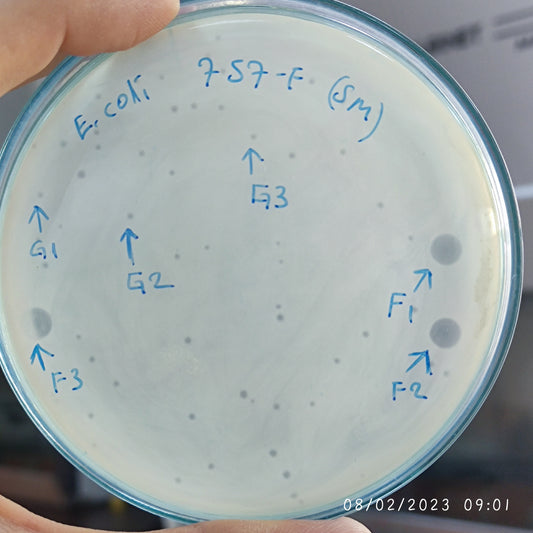
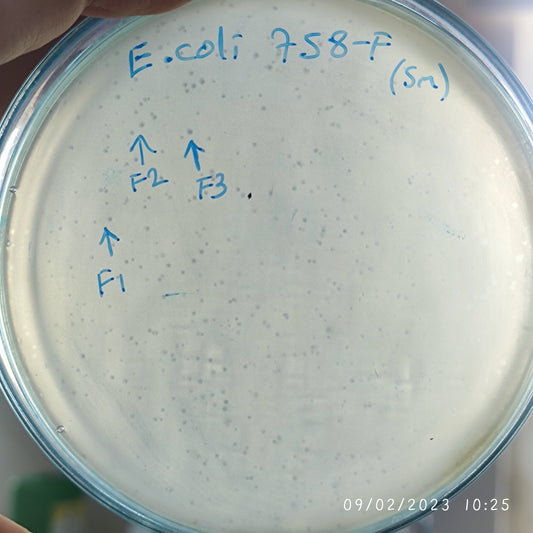
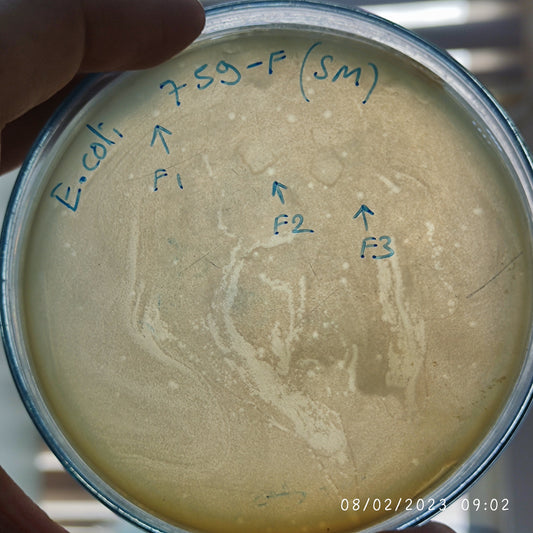
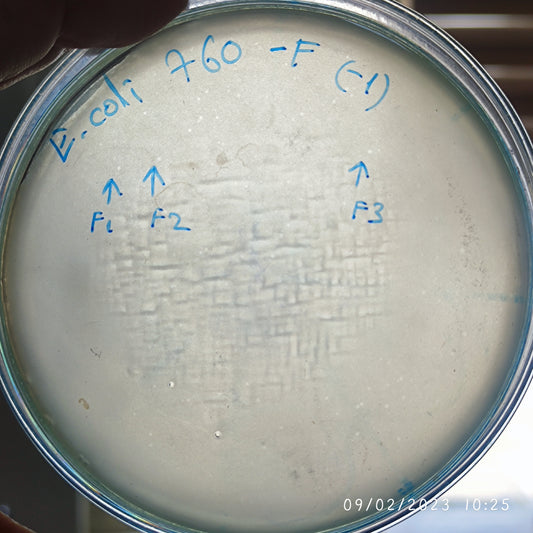
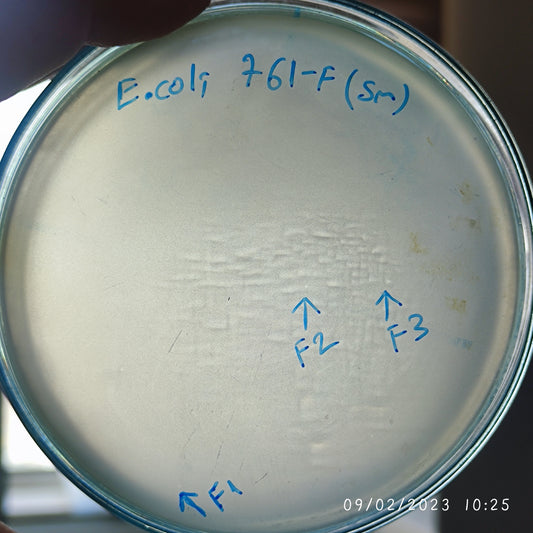
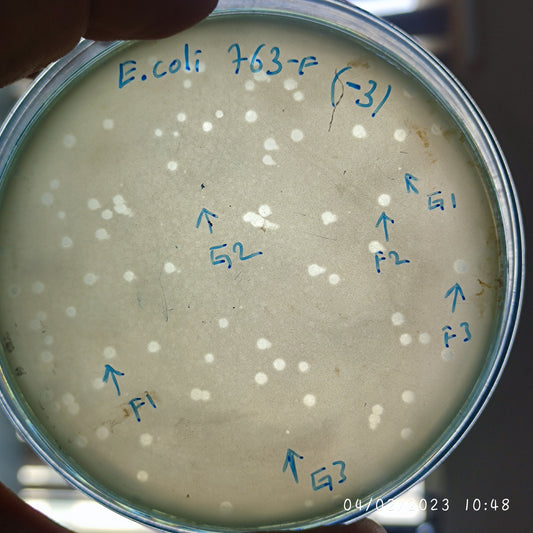
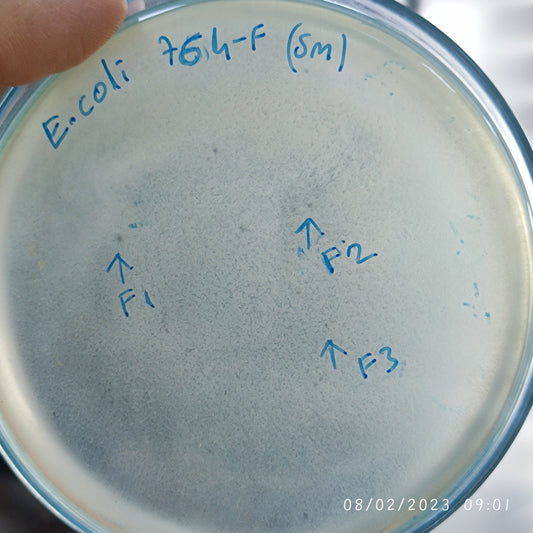
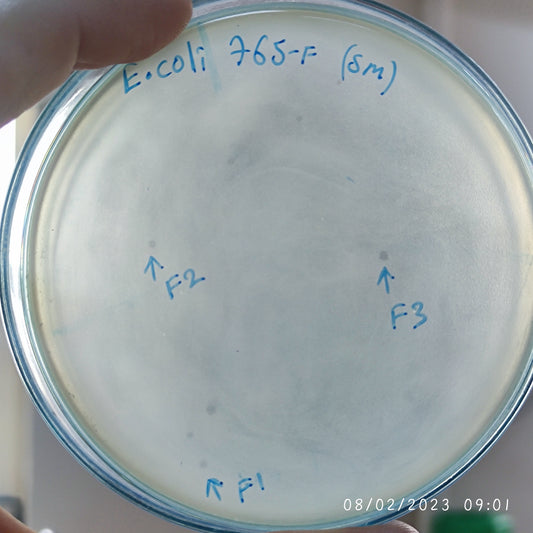
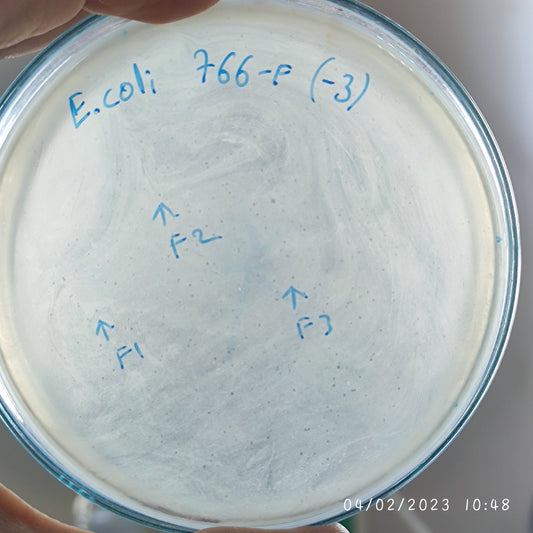

-
Escherichia coli bacteriophage 100749F
Regular price $750.00 USDRegular priceUnit price per -
Escherichia coli bacteriophage 100750F
Regular price $500.00 USDRegular priceUnit price per -
Escherichia coli bacteriophage 100752F
Regular price $600.00 USDRegular priceUnit price per -
Escherichia coli bacteriophage 100753F
Regular price $750.00 USDRegular priceUnit price per -
Escherichia coli bacteriophage 100754F
Regular price $500.00 USDRegular priceUnit price per -
Escherichia coli bacteriophage 100757F
Regular price $750.00 USDRegular priceUnit price per -
Escherichia coli bacteriophage 100757G
Regular price $750.00 USDRegular priceUnit price per -
Escherichia coli bacteriophage 100758F
Regular price $750.00 USDRegular priceUnit price per -
Escherichia coli bacteriophage 100759F
Regular price $650.00 USDRegular priceUnit price per -
Escherichia coli bacteriophage 100760F
Regular price $650.00 USDRegular priceUnit price per -
Escherichia coli bacteriophage 100761F
Regular price $700.00 USDRegular priceUnit price per -
Escherichia coli bacteriophage 100763F
Regular price $750.00 USDRegular priceUnit price per -
Escherichia coli bacteriophage 100763G
Regular price $750.00 USDRegular priceUnit price per -
Escherichia coli bacteriophage 100764F
Regular price $650.00 USDRegular priceUnit price per -
Escherichia coli bacteriophage 100765F
Regular price $700.00 USDRegular priceUnit price per -
Escherichia coli bacteriophage 100766F
Regular price $600.00 USDRegular priceUnit price per